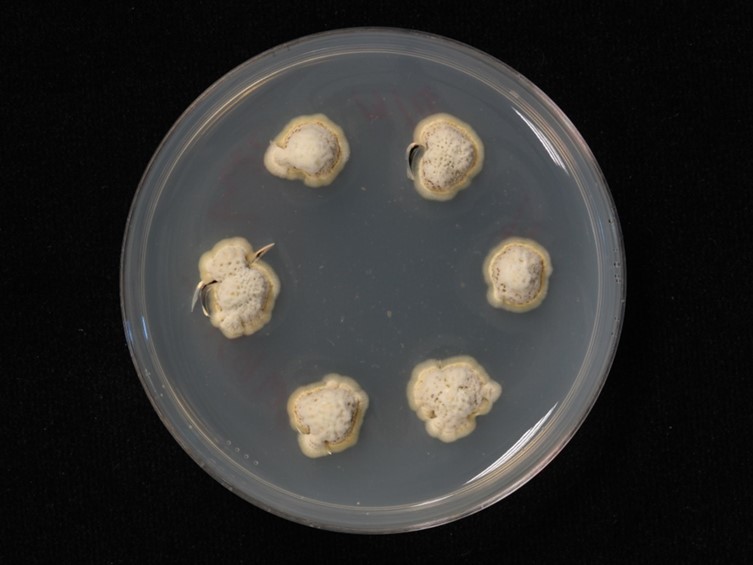

Holotype:
THAILAND, Petchaburi Province, Kaeng Krachan National Park, 19 Sep. 2000, R. Nasit, P. Lutthisungneon, S. Sivichai, B. Tongnuch, W. Tongsridam, holotype BBH 14102, ex-type living culture BCC 8407.
Habitat:
Underside of dicotyledonous leaves.
Host:
Scale insects (Hemiptera).
Description:
 Sexual morph: stromata discoid to pulvinate, up to 2 mm diam and 1.5 mm high, upper surface rounded, pale brown.
Sexual morph: stromata discoid to pulvinate, up to 2 mm diam and 1.5 mm high, upper surface rounded, pale brown.  Perithecia immersed, with ostioles slightly projecting, translucent, scattered, flask-shaped, ca 350 μm high and 120-150 μm diam.
Perithecia immersed, with ostioles slightly projecting, translucent, scattered, flask-shaped, ca 350 μm high and 120-150 μm diam.  Asci 8-spored, up to 150 × 7.5-9 μm.
Asci 8-spored, up to 150 × 7.5-9 μm.  Ascospores whole, non-fragmenting, 80-100 × 1-1.5 μm, blunt at distal end, basally tapering to a tail.
Ascospores whole, non-fragmenting, 80-100 × 1-1.5 μm, blunt at distal end, basally tapering to a tail.  Asexual morph: stromata discoid to pulvinate,
Asexual morph: stromata discoid to pulvinate,  conidiomata pycnidial with dark-brown ostioles, globose, up to 250 μm diam and 350 μm high.
conidiomata pycnidial with dark-brown ostioles, globose, up to 250 μm diam and 350 μm high.  Conidiogenous cells phialidic cylindrical up to 25 μm long.
Conidiogenous cells phialidic cylindrical up to 25 μm long.  Pycnidial paraphyses linear, filiform, flexuous, up to 175 μm long, 1.5-2 μm wide.
Pycnidial paraphyses linear, filiform, flexuous, up to 175 μm long, 1.5-2 μm wide.  Conidia narrow, 10-15 × 2-2.5 μm.
Conidia narrow, 10-15 × 2-2.5 μm.
Culture characteristics:
Colonies on PDA slow-growing, attaining 5–6mm diam after 4 wk, pale reddish brown pigment appearing around old colonies in PDA. Optimal temperature 20–25 °C. Stromatic colonies pale brown to grey-brown, forming compact stromata. Conidial masses pale yellow, appearing as abundant slime masses from immersed pycnidia scattered over the surface.
Colonies on PDA slow-growing, attaining 5–6mm diam after 4 wk, pale reddish brown pigment appearing around old colonies in PDA. Optimal temperature 20–25 °C. Stromatic colonies pale brown to grey-brown, forming compact stromata. Conidial masses pale yellow, appearing as abundant slime masses from immersed pycnidia scattered over the surface.
Reference:
Mongkolsamrit S, Luangsa-ard JJ, Spatafora JW, et al. (2009). A combined ITS rDNA and beta-tubulin phylogeny of Thai species of Hypocrella with non-fragmenting ascospores. Mycological Research 113: 684–699.
DOI: https://doi.org/10.1016/j.mycres.2009.02.004Species |
Strain |
Compound |
Pubchem CID |
Biological activity |
Reference |
|---|
|
Strain |
ITS | β-tubulin |
|---|---|---|
| BCC 17497 | DQ365846 | EU409568 |
| BCC 19360 | EU409592 | EU409578 |
| BCC 8105 | DQ365831 | EU409567 |
| BCC 8407 | DQ365830 | - |
| BCC 8771 | DQ365844 | EU402610 |
| BCC 8772 | EU409585 | - |